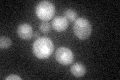
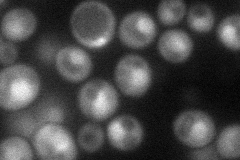
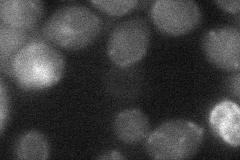

View description
Stimulates the ATPase and helicase activities of Prp43p; acts with Prp43p to stimulate 18s rRNA maturation by Nob1p; overexpression antagonizes the suppression of splicing defects by spp382 mutants; component of pre-ribosomal particles
Localization:
Intensity:
Fold change:
Significance:
-
C’ GFP library in SD
nucleus25.94 -
N' NOP1pr-GFP in SD
cytosol,nucleus62.5345 -
N' TEF2pr-mCherry in SD

missing0 -
N' NATIVEpr-GFP in SD

nucleus29.0495 -
N' TEF2pr-VC and Cyto-VN in SD
below threshold25.477 -
C’ GFP library in SD+DTT

nucleus27.581.06No -
C’ GFP library in SD+H2O2

nucleus26.21No -
C’ GFP library in Starvation Media

nucleus19.210.74Yes -
C’ GFP library on the background of Pup2-DaMP

nucleus -
C’ GFP library on the background of CCT mutant

nucleus27.86081.07356No
